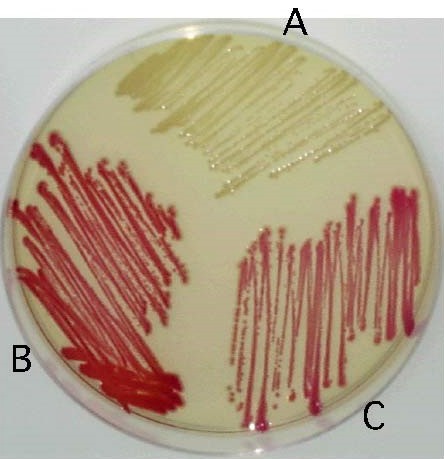
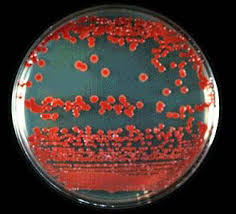

| |
1:感染症とは
(1)セラチア菌
①セラチア菌とは
大腸菌や肺炎桿菌などに近い細菌で、日和見感染による院内感染の原因菌の一つです。
グラム陰性の非芽胞形成通性嫌気性の桿菌で真正細菌の一属です。
腸内細菌科に属し、90%以上がセラチア・マルセッセンスです。
動物の死骸からよく検出されるため、日本では霊菌とも呼ばれる事もあります。
G(-)嫌気性桿菌 G(-)嫌気性桿菌
②存在場所
水や土など自然界に広く分布しています。
また、食物に付着して増殖することがあります。
ヒトや動物の腸内にいる常在菌でもあります。
洗面台や排水溝など、湿潤した水回りの環境に存在します。
セラチアは赤色からピンクの色素を産生することが多く、洗面台などにバイオフィルムを形成しているのが
見えることがあります。

③特徴
赤色からピンクの色素を産生することが多い.
好発時期は梅雨時期~夏期にかけた時期です。
本来、病原性は弱い細菌です。
(2)セラチア菌感染症
セラチアは、蜜蜂に感染すると、蜂が死ぬ事がありますが、人に対しては弱毒性です。
健常者の場合、セラチアが皮膚に付いたり、たとえ口から入っても、腸炎や肺炎、敗血症などの病気(感染症)に
なることはありません。
セラチアの感染が問題となるのは、手術の後や重篤な疾患などが原因で感染防御能力が低下した際の感染症、
いわゆる日和見感染症で、特にセラチアが血液、腹水、髄液などから分離される場合です。
そのような場合には、セラチアが産生するエンドトキシンにより血圧が急激に下がったり(ショック状態)また、
その結果、腎臓や肝臓の機能が障害され、多臓器不全という状態に陥ると、死亡する危険性が高くなります。
2:感染様式
(1)感染経路
接触感染です。
(2)感染例
①)手指を経由した伝播
院内の湿潤環境に広く分布していいます。
症状のない尿路保菌者などにも存在するので、医療従事者の手指を頻繁に汚染することがあります。
②薬剤を経由した伝播
セラチア菌は栄養源の乏しい水の中でも増殖する。
不適切に操作された点滴や点滴のチューブに、セラチア菌が生息することがある。
消毒薬にも存在することがある。
③医療器具や物品を経由した伝播
④環境を経由した伝播
床などの乾燥環境ではあまり問題とならない.
洗面台の湿潤環境においては、そこに生息するセラチア菌が感染源となる可能性がる。
液体石けんのノズルにもくっついていることがあります。
(3)セラチアが血液などに侵入する原因・経路
①内因性感染
癌の末期や極度の免疫不全状態などでは、腸管内に常在していたセラチアが血液に侵入し菌血症や
敗血症を起こします。
②感染症に伴う場合
腎盂炎などの際に腎臓から血液に菌がはいる場合。
肺炎や創部感染になどに伴って、菌血症や敗血症になる場合。
③外因性感染
セラチアにより汚染された注射剤や輸液ルートが原因で、血液中に菌が人為的に侵入する場合。
3:疫学
(1)セラチア菌が感染し易い人
セラチア菌は主に体力・免疫力の弱まった人たちに感染症を起こすことがある細菌と見なされています。
4:症状
(1)臨床的特徴
人に対しては非常に毒性が弱い菌種です。
健常成人の場合、セラチアが皮膚に付いたり、口から入ったりしても、腸炎や肺炎、敗血症などの病気になる
ことはまず有りません。
セラチア菌が血液、腹水、髄液で繁殖してしまうことが問題となります。
そのような場合には、セラチアが産生する毒素により血圧が急激に下がったりします。
その結果、腎臓や肝臓の機能が障害され多臓器不全という状態に陥ったりする場合があります。
その際には死亡する危険性が非常に高くなります。
(2)セラチア菌と各種感染症
のどや気道にくっつきやすいため、肺炎が代表的な感染症です。
尿路感染、カテーテル関連菌血症(各種カテーテル・チューブを介して血液の中に菌が入り込んでいる状態)、
手術後創部感染がよく見られます。
その他、軟部組織感染症(皮膚や皮下組織に起こる感染症)、骨髄炎、眼内炎などが報告されています。
セラチア菌によって次の様な感染症が発症します。
尿路感染症、気道感染症、心内膜炎、骨髄炎、敗血症、傷の感染症、目の感染症、髄膜炎など
5:診断
6:治療
(1)薬物療法
本菌による感染症の治療には、セフェム系、カルバペネム系、ニューキノロン系などが用いられます。
しかし最近では、抗菌薬耐性遺伝子を獲得することでこれらの抗菌薬が効かなくなっ「多剤耐性セラチア
も分離されています。
7:感染予防法
(1)消毒薬
1%次亜塩素酸ナトリウム、70%のエタノール、2%のグルタルアルデヒド、ホルムアルデヒド、ヨード剤など
が有効。
塩化ベンザルコニウムは効きにくかったり、クロルヘキシジンなどは無効な場合があります。
詳細は、「消毒・滅菌」、「消毒薬類について」、「各種消毒薬の選択」 へ
(2)手洗い
石けんと流水による手洗いを十分に行えば有効です。
無菌操作を必要とする場合は手指消毒剤を使用します。
(3)器具の消毒・乾燥
使用の用途に合わせた消毒薬を使用します。
また、洗った後はよく乾燥させて下さい。
(4)物品の管理
水回りの用具は、しっかり洗い流して乾燥させます。
(5)薬剤の衛生管理
輸液の調剤は使用直前に行います。
開封日の記入、清潔な保管場所の確保を行う事が必要です。
|